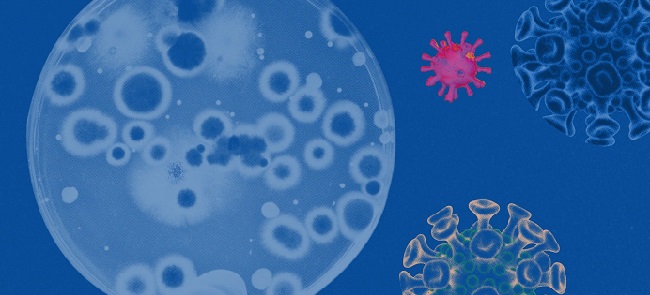

ନୂଆଦିଲ୍ଲୀ,୩ ।୧୨: କରୋନା ଭାଇରସର ନୂଆ ଭାରିଏଣ୍ଟ ଓମିକ୍ରନ୍ ଏବେ ଭାରତରେ ପହଞ୍ଚି ସାରିଲାଣି । କର୍ନାଟକରେ ଓମିକ୍ରନ୍ ସଂକ୍ରମିତ ୨ ଜଣ ବ୍ୟକ୍ତିଙ୍କୁ ଚିହ୍ନଟ କରାଯିବା ପରେ ଏବେ ସାରା ଦେଶରେ ଓମିକ୍ରନ୍କୁ ନେଇ ଚିନ୍ତା ବଢି ଯାଇଛି । ଏହାରି ଭିତରେ ମେଦାନ୍ତ ହସ୍ପିଟାଲର ସଂସ୍ଥାପକ ଡା. ନରେଶ ତ୍ରେହାନ ଓମିକ୍ରନ୍କୁ ନେଇ କିଛି ତଥ୍ୟ ଦେଇଛନ୍ତି । ସେ କହିଛନ୍ତି ଜଣେ ଓମିକ୍ରନ୍ ସଂକ୍ରମିତ ବ୍ୟକ୍ତି ୧୮-୨୦ ଜଣଙ୍କୁ ପଜିଟିଭ କରିପାରେ । ଏହାର କାରଣ ହେଉଛି ଅନ୍ୟ ଭାରିଏଣ୍ଟ ତୁଳନରେ ଓମିକ୍ରନ୍ର ଆର୍ ନଟ୍ ଭାଲ୍ୟୁ ବହୁ ଅଧିକ । ତେବେ ଏହି ଓମିକ୍ରନ୍ ଭାରିଲଣ୍ଟକୁ ନେଇ ଆମେ ଭୟଭୀତ ହେବା ପରିବର୍ତ୍ତେ ନିଜେ ସତର୍କ ରହିବା ଜରୁରୀ । ଏହାସହ ଓମିକ୍ରନ୍ଠାରୁ କେବଳ ଟିକା ହିଁ ଆମକୁ ସୁରକ୍ଷା ଦେଇପାରିବ ବୋଲି ସେ କହିଛନ୍ତି ।

















